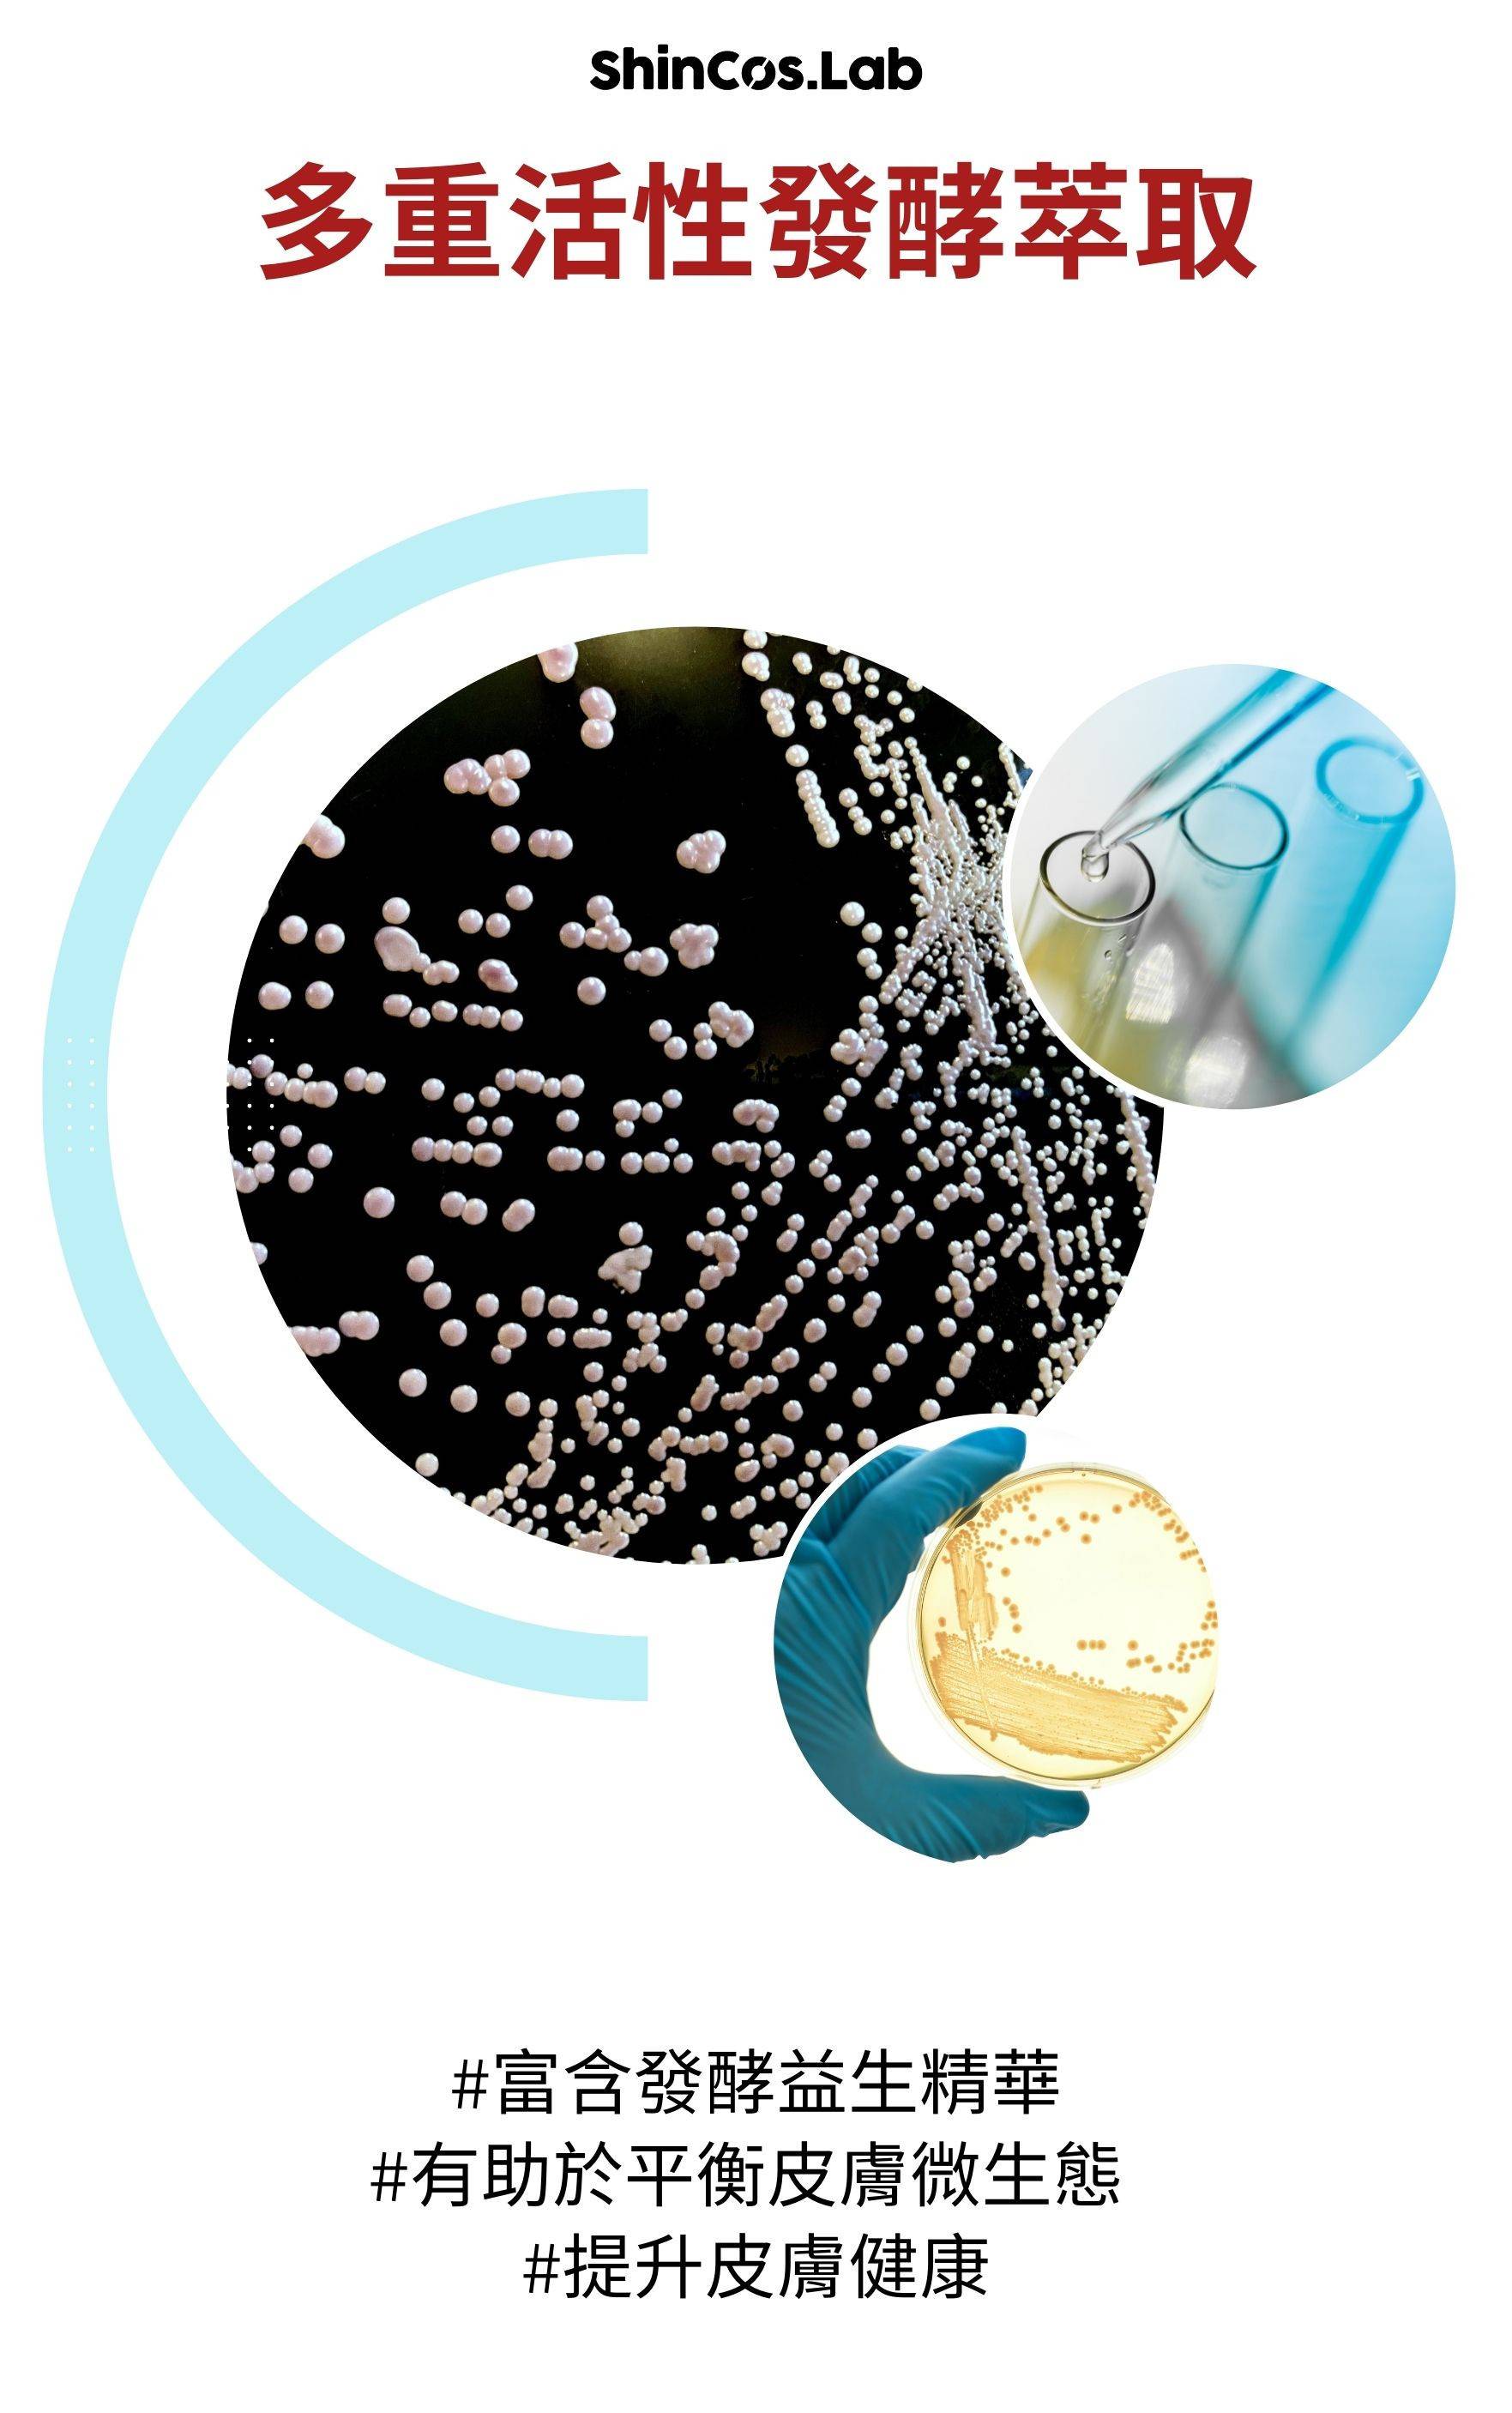

商品詳情

三大核心成分
透明質酸(玻尿酸)
菸鹼醯胺
泛醇B5
 純素產品定義
純素產品定義
不添加動物性原料
產品不得在動物身上進行測試產品成分
原材料不應在動物身上進行測試
 容量:60/片
容量:60/片
核准字號:一般化妝品經核准免衛生署登記
用途:高效提升皮膚保水度,調理肌膚紋路,提升皮膚飽滿晶亮
用法:清潔後,可用於臉部保濕、降溫,深層滋潤肌膚
有紋理面可用於去角質,全身粗糙、乾燥部位皆可使用
也可放置冰箱冰涼保存,使用時再取出
保存方法:放置陰涼處,避免陽光直曬
全成分:包裝上
使用注意事項:使用若有不適請停止使用,並向皮膚科醫師諮詢
原產地:韓國
製造日期及保存期限:如外盒及瓶身所示
有效期限:三年 批號:標示於產品瓶身及外包裝上
【ShInCos.Lab】透明質酸(玻尿酸)B5 3% 去角質保濕棉片
TWD $780




